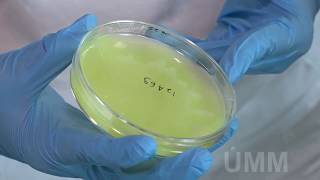

Talajoltó termékek
Termésbiztonság és tervezhető hozam minden esetben

Szárbontó termékek
Szármaradványok elbontása, a bennük lévő tápanyag feltárása

Biostimulátorok, gombák
Növényizgatás felsőfokon

Lombtrágyák
Makro és mikroelemek biztosítása az egészséges és fejlett növényekért

Kijuttatási eszközök
A baktériumtrágyák kijuttatása nagy odafigyelést igénylő feladat a gazdálkodó részére, mivel egy élő anyagról van szó és a talajbaktériumok számára a legnagyobb stressz a talajba való visszakerülés. Ezért a BactoFil törzseit megfelelő mikroelem mixel támogatják -gyártásuk során- a kezdeti gyors...

Termékpárok
Aktuális akciók